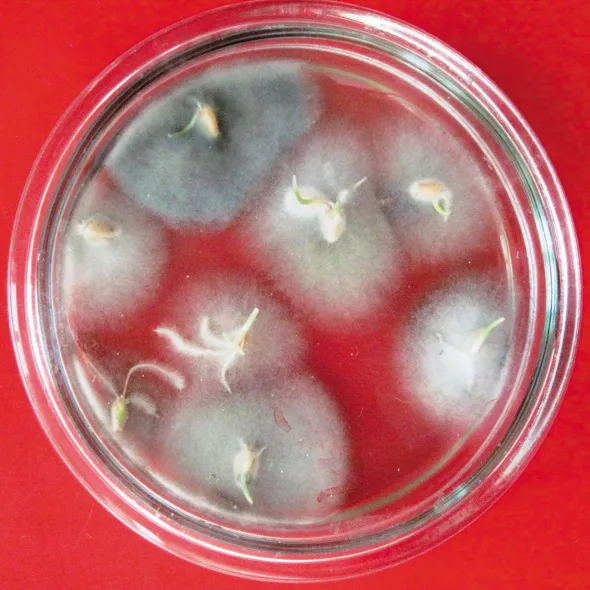

Хвороби насінин
Фузаріоз. Причинами хвороби виступають гриби з роду Fusarium Link. Хворе зерно відрізняється зморщеністю та блідим відтінком. На його поверхні здатні утворюватися рожевуваті чи помаранчеві подушечки — спороутворення збудника. При цьому, залежно від умов і часу ураження, видимі ознаки хвороби можуть бути різними або зовсім непомітними.
Інфікування зерна грибами роду Fusarium під час росту рослин відбувається за умов збільшеної вологості і температури повітря під час збору врожаю. Інфіковане зерно втрачає або має знижену здатність до проростання. Окрім того, в ньому збираються мікотоксини. Важливо пам’ятати, що причини фузаріозу здатні розвиватися у вологому зерні під час його зберігання.

Різний ступінь ураження насіння пшениці фузаріозом
Одним із джерел зараження фузаріозом є зерно, в якому знаходиться грибниця збудника і конідії на його оболонці. В цілому фузарієві гриби розрізняються між собою міжвидовою патогенністю, мають широку спеціалізацію. Переважання того чи іншого збудника буде залежати від екологічних чинників. При висіві зерна з прихованою формою зараження фузаріозом настає загибель проростків, поява кореневої гнилі. Культури, які вижили, стають слабкими і більш схильними до інших недуг.
Чорний зародок. Патологія зерна пшениці та інших злакових культур має складний характер. Серед їх збудників поширені гриби з роду Alternaria Nees. та Bipolaris sorokiniana (Sacc.) Shaem. Зерно ячменю може бути інфіковане також грибом Drechslera graminea Ito. (Pyrenophora graminea Ito et Kuribayashi).
Альтернаріозний чорний зародок визначається потемнінням насінини в ділянці зародка або безпосередньо зародкового щитка. Воно може розповсюджуватись на будь-яку частину зернини, при цьому її колір змінюється від темно-коричневого до оливкового, а наповненість зернівки може зберігатись. Грибниця Alternaria alternata (Fries) Keissl. зосереджена у плодовій оболонці зерна, частіше під зародком і тільки інколи потрапляє в ендосперм. Під час проростання хворої насінини спостерігають такі ознаки: деформація паростка, виникнення повітряного міцелію (сірого, мишачого або попелястого кольору), потемніння первинних корінців, кореневої шийки і основи стебла. Частота проникнення грибів з роду Alternaria на зерно буває досить високою, тим не менш, інфекція є поверхневою.
У зараженого зерна В. sorokiniana спостерігають характерну темну пігментацію в зоні зародка. Грибниця збудника потрапляє в перикарп, ендосперм і часто в зародок. Хворе зерно щупле.

Чорний зародок насіння: загальний вигляд уражених насінин
Чорний зародок насіння: хворе насіння під час пророщування
Найчастіше зерно, вражене чорним зародком, є фізіологічно недорозвиненим і має низьку продуктивність проростання та схожість. Культури, сформовані з таких насінин, відстають у зростанні та розвитку і часто є причиною появи звичайної кореневої гнилі, що істотно зменшує врожай.
Гриб А. аlternatа розвивається на зів’ялих рослинних залишках і паразитує на багатьох видах рослин. В. sorokinianа паразитує на рослинах різних систематичних груп — злакових, бобових, пасльонових, складноцвітних та ін. Основне джерело зараження — вражене зерно і рештки, в яких збудники хвороби зберігаються у вигляді грибниці та конідій на поверхні.
Пліснявіння. Якість насіння здатні знижувати мікроміцети родів Mucor Mich. emend Ehrenb, Penicillium Link., Aspergullus Michel., Epicoccum Link та інших.
Їхня шкідливість обумовлена головним чином несприятливими умовами в період дозрівання врожаю, зберігання і появи сходів рослин. Цьому сприяють підвищена вологість, низькі температури, а також пошкодження зерна. Rhizopus spp. формує павутинну, згодом — ватоподібну повітряну колонію, яка швидко вкриває поверхню насінин. Колонія гриба має білий або сіруватий колір; на ній помітні чорні крапки — спороношення (спорангії). Через поразку Mucor spp. на насінні з’являється сіро-зелений або темно-бурий наліт. Penicillium spp. в умовах збільшеної вологості повітря розвивається на насінні у вигляді пліснявого нальоту зелено-сизого кольору. Aspergillus spp., колонізуючи зерно, викликає на його поверхні маленькі порошисті головки. Epicoccum spp. формує на поверхні насіння спороношення у вигляді чорних порошистих подушечок. Наслідком негативного впливу грибів, які обумовлюють пліснявіння, є зниження схожості зерна, загибель проростків і ослаблення рослин.

Проявлення пліснявіння під час пророщування насіння

Проявлення пліснявіння під час пророщування насіння

Проявлення пліснявіння під час пророщування насіння
Кореневі гнилі
Фузаріозна коренева гниль. Причинами захворювання виступають гриби з роду Fusarium Link. Видовий склад збудників у різних еколого-географічних зонах може змінюватись. Багато в чому він залежить і від попередника вирощуваної культури.
Уражуються культури різного віку, недуга може викликати відмирання проростків до досягнення ними поверхні ґрунту, а також обумовлює побуріння первинних і вторинних корінців, підземного міжвузля та основи стебла. На уражених органах рослин спочатку виникають бурі, коричневі штрихи або смуги, які потім розростаються, часто зливаються і охоплюють їх. У період росту стають рідшими посіви.
Збудники, що викликають хворобу, розвиваються в широкому температурному діапазоні (від 3 до 35 °С) та вологості. Інфікування рослин можливе при вологості ґрунту понад 40 % повної вологоємності. Сильніше уражуються ослаблені рослини із зниженим тургором, що обумовлено нестачею вологи.
Основне джерело зараження — ґрунт, в якому на уражених рештках збудники зберігаються у вигляді грибниці, хламідоспор і склероціїв. Додатковим джерелом зараження є заражене зерно.

Рослини, уражені збудниками кореневих гнилей

Рослини, уражені збудниками кореневих гнилей

Рослини, уражені збудниками кореневих гнилей
Звичайна, або гельмінтоспоріозна, коренева гниль. Збудником хвороби є гриб Bipolaris sorokiniana Shoem. (Cochliobolus sativus (Ito et Kuribayashi) Drechsler ex Dastur.). Захворюванню характерне побуріння, деформація і викривлення проростків, які часто гинуть до виходу колеоптиле на поверхню ґрунту. При появі сходів на піхві першого листка, а згодом — в основі стебла утворюються бурі смуги і плями. Залежно від міри розвитку хвороба може призвести до зрідження посівів.
Збудник деякий час може розвиватися як сапротроф на рослинних залишках, утворюючи темно-бурі дернинки грибниці, а при достатній вологості – і конідієносці з конідіями.
Розвитку хвороби сприяють різкі перепади температури і вологість повітря та ґрунту, посуха, недотримання агротехніки, монокультура пшениці, пошкодження рослин шкідниками (в основному злаковими мухами).
Основне джерело зараження — вражені рештки і зерно, де гриб зберігається завдяки грибниці і конідіальному спороношенню. Збудник також уражує ячмінь, слабкіше — жито. Накопичення інфекції обумовлюють дикорослі злаки (костриця, мишій, пирій, тимофіївка та ін.).
Борошниста роса
Збудником хвороби на пшениці є гриб Blumeria graminis (DC.) Speer f. sp. tritici Marchal. (синонім Erysiphe graminis DC.). Ячмінь, зокрема всі надземні органи рослин, уражує Blumeria graminis f. sp. hordei. Перші симптоми захворювання спостерігають уже восени. На сходах борошниста роса помітна на піхвах листків у вигляді матових плям, а потім — у вигляді білого павутинного нальоту, який ущільнюється і перетворюється у ватоподібні подушечки. Згодом наліт поширюється на листкову пластинку, частіше з верхнього, а іноді з обох боків.

Проявлення борошнистої роси на пшениці озимій

Проявлення борошнистої роси на пшениці озимій

Проявлення борошнистої роси на пшениці озимій
Збудник борошнистої роси для свого розвитку не вимагає краплинно-рідинної вологи, але йому потрібна висока відносна вологість повітря (оптимальною є вище 80 %). Оптимальна температура становить 14…17 °С. В умовах посухи, високих температур і при їхніх перепадах у рослин слабшає тургор, що супроводжує зростання їхньої сприйнятливості до борошнистої роси. У сильно уражених рослин знижується кущіння.
Посіви озимини ранніх термінів посіву уражуються сильніше, ніж оптимальних.
На озимих культурах збудник борошнистої роси зимує у вигляді поверхневої грибниці, переважно у піхвах листків. Додатковим джерелом зараження є клейстотеції на уражених рослинних рештках.
Септоріоз пшениці
Збудниками хвороби є гриби Phaeosphaeria nodorum (E. Muell.) Hedjar, Mycosphaerella graminicola (Fuckel) J. Schroet та ін. Захворювання проявляється у вигляді плямистостей на листках, стеблах і колосі. Перші її симптоми можна спостерігати восени на уражених сходах рослин. На листкових пластинках утворюються дрібні хлоротичні або трохи жовтуваті плями. Спочатку вони мають нечіткий контур і слабко розрізняються за кольором від основної зеленої тканини листка. Згодом центр плям стає попелясто-сірим і на ньому чітко видно темно-коричневі з глянцевим відтінком крапки, що є пікнідами збудника.
Швидкий розвиток септоріозу спостерігають при частих дощах і за температури 20…25 °С зі слабкими вітрами. Пікноспори проростають у краплі води або за умов 100 % відносної вологості повітря.

Симптоми септоріозу на листках пшениці озимої

Симптоми септоріозу на листках пшениці озимої

Симптоми септоріозу на листках пшениці озимої
Основними джерелами зараження є уражені листки сходів озимини і рослинні рештки, де збудник зимує у вигляді пікнід. На залишках уражених рослин формуються псевдотеції. Додаткові джерела зараження — уражене зерно, в якому зберігається грибниця і уражені дикорослі та культурні злаки.
Плямистості листя ячменю
Сітчаста плямистість. Збудником хвороби є гриб Pyrenophora teres Drechsler (Drechsle rateres Ito). У період кущіння рослин захворювання виявляють на листках. Його симптоми характеризуються утворенням овальних бурих плям, тканина навколо яких набуває хлоротичного відтінку. Характерною ознакою сітчастої плямистості, за якою можна візуально її діагностувати, є формування на уражених ділянках темно-коричневих поздовжніх і поперечних смуг, які утворюють ніби сітчастий малюнок. У вологу погоду на плямах з’являється темно-сірий наліт, що складається з конідіального спороношення збудника. Максимального розвитку сітчаста плямистість досягає під час цвітіння і наливання зерна. Інтенсивний розвиток хвороби призводить до масового відмирання листків, що обумовлює зниження продуктивності рослин.
Однією з причин частих спалахів хвороби є велика кількість інфекційного матеріалу в природних умовах, зокрема, уражені рослинні рештки ячменю. Інфекцію також може містити насіння. Особливістю гриба P. teres є висока життєздатність і стійкість проти абіотичних факторів його міцелію і конідій. На уражених рештках збудник також продукує сумчасту стадію.
У період росту рослин хвороба інтенсивніше розвивається за тривалого періоду наявності високої відносної вологості повітря.

Темно-бура плямистість ячменю

Сітчаста плямистість ячменю

Смугаста плямистість ячменю
Смугаста плямистість. Захворювання викликає гриб Pyrenophora graminea Ito & Kuribayashi (Drechsler agraminea Ito). Хвороба проявляється від початку появи сходів, на другому або третьому листках проростків і надалі впродовж усього періоду росту рослин. Діагностичні ознаки захворювання на сходах характеризуються виникненням на листках спочатку блідо-жовтих плям, які по мірі розвитку подовжуються, некротизуються і зливаються в світло-коричневі смуги.
При високій вологості повітря на уражених ділянках утворюється оливково-бурий наліт, що являє собою конідіальне спороношення збудника. Слід відзначити, що візуально явище наявності нальоту на поверхні плям спостерігають не у всіх випадках.
Інтенсивного розвитку смугаста плямистість досягає під час цвітіння та наливання зерна. Масове ураження листків призводить до їх загибелі і зниження продуктивності рослин. Інфіковане зерно може втрачати посівні якості.
На ураження рослин збудником і подальший розвиток смугастої плямистості впливають метеорологічні умови. Зокрема, продукування інфекційного матеріалу відбувається при високій вологості повітря. Однобічне внесення азотних добрив обумовлює посилення смугастої плямистості.
Джерелом зараження є залишки уражених рослин. Міцелій і конідії гриба зимують у ґрунті, інфекція може знаходитися всередині інфікованих насінин.
Темно-бура плямистість. Збудником хвороби є гриб Bipolaris sorokiniana (Sacc.) Shoem. Окрім плямистості листя, збудник уражує також кореневу систему, колос і зерно. Захворювання проявляється впродовж усього періоду вегетації. Перші його ознаки можна виявити на сходах, у яких часто утворюється один корінець замість трьох. На корінцях, колеоптиле і перших листках з’являються поздовжні темні плями у вигляді штрихів і смужок, паростки викривляються і гинуть. Водночас симптоми хвороби є мінливими і залежать від багатьох факторів: сорту, умов довкілля, фази розвитку рослин. На листках дорослих рослин виникають спочатку темні, а потім темно-сірі або світло-бурі плями, трохи подовжені вздовж листків, у центрі вони світліші, з темною облямівкою. У вологу погоду на уражених ділянках формується оливково-бурий або чорно-сірий наліт. При сильному розвитку хвороби плями зливаються і вкривають весь листок. Можуть уражуватися також нижні вузли стебла, які загнивають, а рослини вилягають. При інтенсивному розвитку хвороби на листках уражується також колос і зерно. На останньому з’являються симптоми чорного зародку.
В уражених рослин знижується загальна і продуктивна кущистість, на них утворюється менше первинних і вторинних коренів. Розвитку хвороби сприяє тепла і волога погода.
Джерелами зараження можуть бути післязбиральні уражені рештки, інфіковані сходи озимини, уражене зерно, а також різні морфологічні структури гриба, що зберігаються в ґрунті. Резервація збудника відбувається на уражених бур’янах (пирії та інших). Гриб B. sorokiniana паразитує також на пшениці та житі.
Заходи щодо запобігання розвитку хвороб
Для обмеження захворювань восени упродовж вегетації рослин важливе значення мають такі агротехнічні заходи: дотримання сівозміни та просторової ізоляції; своєчасний збір ярих культур; лущення стерні; ранній обробіток ґрунту; збалансована система удобрення; знищення бур’янів і ліквідація сходів падалиці. Все це є важливими агроприйомами, оскільки такі рослини є резерватором інфекції різних збудників хвороб. Оптимальні терміни посіву також зменшують поширення захворювань на рослинах. Слід враховувати, що надмірно ранні посіви сильніше уражуються бурою листковою іржею і сніговою пліснявою. Під час проростання зерна в осінній період відбувається інфікування проростків пшениці та ячменю збудниками твердої сажки. Тому, наприклад, пшениця озима при пізньому посіві сильніше уражується твердою сажкою.
Із збільшенням глибини заорювання зерна зростає уражуваність рослин твердою сажкою, а також збудником звичайної кореневої гнилі.
Велике значення в обмеженні розвитку хвороб має підвищення якості насіннєвого матеріалу. Тому ретельна підготовка зерна до посіву, сортування, очищення його від смітної домішки знижують ураженість рослин. До того ж важливим заходом в обмеженні хвороб є знезараження насіння. Хімічне знезараження здійснюють із застосуванням препаратів для протруювання зерна. Згідно з Переліком пестицидів і агрохімікатів, дозволених до використання в Україні на сьогодні в Україні дозволено застосування протруйників різного спектру дії, що містять одну або декілька діючих речовин, які забезпечують контроль збудників сажкових хвороб, кореневих гнилей, пліснявіння зерна та ін. Загалом протруйники можуть підвищувати схожість некондиційних, але з високою життєздатністю насінин, а також сприяють зменшенню шкідливого впливу ґрунтової інфекції на проростки пшениці. Використання хімічних і біологічних протруйників має базуватись на результатах фітопатолочіної експертизи насіннєвого матеріалу, що дає змогу оптимально підібрати препарат із врахуванням видового складу збудників, їхньої біології і місця локалізації (екзофітної, або ендофітної інфекції).
Для прийняття рішення щодо застосування проти захворювань фунгіцидів слід враховувати фітосанітарний стан поля, а також агроекологічні та економічні чинники.
М. Кирик, д-р біол. наук, М. Піковський, канд. біол. наук
